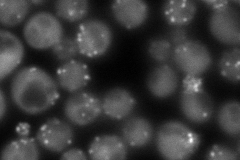
YGR080W
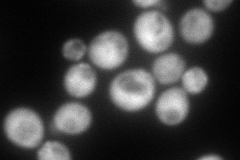
YGR080W
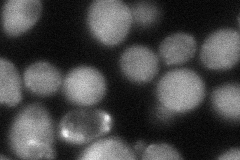
YGR080W
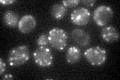
YGR080W

View description
Twinfilin, highly conserved actin monomer-sequestering protein involved in regulation of the cortical actin cytoskeleton, composed of two cofilin-like regions, localizes actin monomers to sites of rapid filament assembly
Localization:
Intensity:
Fold change:
Significance:
-
C’ GFP library in SD

punctate28.49 -
N' NOP1pr-GFP in SD
punctate,bud neck161.392 -
N' TEF2pr-mCherry in SD
cytosol,bud neck191.168 -
N' NATIVEpr-GFP in SD

punctate,bud neck46.5293 -
N' TEF2pr-VC and Cyto-VN in SD
punctate,bud neck54.6055 -
C’ GFP library in SD+DTT

punctate46.31.62Yes -
C’ GFP library in SD+H2O2

punctate35.861.25No -
C’ GFP library in Starvation Media
punctate63.352.22Yes -
C’ GFP library on the background of Pup2-DaMP

punctate -
C’ GFP library on the background of CCT mutant

punctate40.09831.40724Yes
